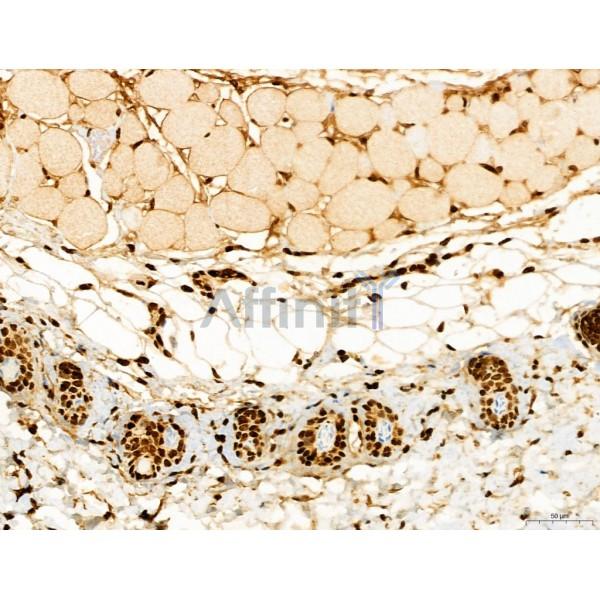
CCP1 Antibody - DF12146 at 1/100 staining Mouse skin tissue by IHC-P.

CCP1 Antibody - #DF12146
| Product: | CCP1 Antibody |
| Catalog: | DF12146 |
| Description: | Rabbit polyclonal antibody to CCP1 |
| Application: | WB IHC |
| Reactivity: | Human, Mouse, Rat |
| Prediction: | Pig, Zebrafish, Bovine, Horse, Sheep, Rabbit, Dog, Chicken, Xenopus |
| Mol.Wt.: | 138 kDa; 138kD(Calculated). |
| Uniprot: | Q9UPW5 |
| RRID: | AB_2844951 |
Related Downloads
Protocols
Product Info
*The optimal dilutions should be determined by the end user. For optimal experimental results, antibody reuse is not recommended.
*Tips:
WB: For western blot detection of denatured protein samples. IHC: For immunohistochemical detection of paraffin sections (IHC-p) or frozen sections (IHC-f) of tissue samples. IF/ICC: For immunofluorescence detection of cell samples. ELISA(peptide): For ELISA detection of antigenic peptide.
Cite Format: Affinity Biosciences Cat# DF12146, RRID:AB_2844951.
Fold/Unfold
CCP1; 1700020N17Rik; 2310001G17Rik; 2900054O13Rik; 4930445M19Rik; 5730402G09Rik; AGTPBP 1; AGTPBP1; ATP/GTP binding protein 1; ATP/GTP-binding protein 1; BB114605; Carboxypeptidase tubulin; CBPC1_HUMAN; Cytosolic carboxypeptidase 1; DKFZp686M20191; KIAA1035; MGC90651; mKIAA1035; Nervous system nuclear protein induced by axotomy; Nervous system nuclear protein induced by axotomy protein 1 homolog; nmf243; NNA1; OTTHUMP00000021581; OTTHUMP00000063553; pcd; Purkinje cell degeneration; RP11-30C23.1; Soluble carboxypeptidase; Tubulinyl Tyr carboxypeptidase; Tyrosine carboxypeptidase;
Immunogens
A synthesized peptide derived from human CCP1, corresponding to a region within the internal amino acids.
- Q9UPW5 CBPC1_HUMAN:
- Protein BLAST With
- NCBI/
- ExPASy/
- Uniprot
MSKLKVIPEKSLTNNSRIVGLLAQLEKINAEPSESDTARYVTSKILHLAQSQEKTRREMTAKGSTGMEILLSTLENTKDLQTTLNILSILVELVSAGGGRRVSFLVTKGGSQILLQLLMNASKESPPHEDLMVQIHSILAKIGPKDKKFGVKARINGALNITLNLVKQNLQNHRLVLPCLQLLRVYSANSVNSVSLGKNGVVELMFKIIGPFSKKNSSLIKVALDTLAALLKSKTNARRAVDRGYVQVLLTIYVDWHRHDNRHRNMLIRKGILQSLKSVTNIKLGRKAFIDANGMKILYNTSQECLAVRTLDPLVNTSSLIMRKCFPKNRLPLPTIKSSFHFQLPVIPVTGPVAQLYSLPPEVDDVVDESDDNDDIDVEAENETENEDDLDQNFKNDDIETDINKLKPQQEPGRTIEDLKMYEHLFPELVDDFQDYDLISKEPKPFVFEGKVRGPIVVPTAGEETSGNSGNLRKVVMKENISSKGDEGEKKSTFMDLAKEDIKDNDRTLQQQPGDQNRTISSVHGLNNDIVKALDRITLQNIPSQTAPGFTAEMKKDCSLPLTVLTCAKACPHMATCGNVLFEGRTVQLGKLCCTGVETEDDEDTESNSSVEQASVEVPDGPTLHDPDLYIEIVKNTKSVPEYSEVAYPDYFGHIPPPFKEPILERPYGVQRTKIAQDIERLIHQSDIIDRVVYDLDNPNYTIPEEGDILKFNSKFESGNLRKVIQIRKNEYDLILNSDINSNHYHQWFYFEVSGMRPGVAYRFNIINCEKSNSQFNYGMQPLMYSVQEALNARPWWIRMGTDICYYKNHFSRSSVAAGGQKGKSYYTITFTVNFPHKDDVCYFAYHYPYTYSTLQMHLQKLESAHNPQQIYFRKDVLCETLSGNSCPLVTITAMPESNYYEHICHFRNRPYVFLSARVHPGETNASWVMKGTLEYLMSNNPTAQSLRESYIFKIVPMLNPDGVINGNHRCSLSGEDLNRQWQSPSPDLHPTIYHAKGLLQYLAAVKRLPLVYCDYHGHSRKKNVFMYGCSIKETVWHTNDNATSCDVVEDTGYRTLPKILSHIAPAFCMSSCSFVVEKSKESTARVVVWREIGVQRSYTMESTLCGCDQGKYKGLQIGTRELEEMGAKFCVGLLRLKRLTSPLEYNLPSSLLDFENDLIESSCKVTSPTTYVLDEDEPRFLEEVDYSAESNDELDIELAENVGDYEPSAQEEVLSDSELSRTYLP
Predictions
Score>80(red) has high confidence and is suggested to be used for WB detection. *The prediction model is mainly based on the alignment of immunogen sequences, the results are for reference only, not as the basis of quality assurance.
High(score>80) Medium(80>score>50) Low(score<50) No confidence
Research Backgrounds
Metallocarboxypeptidase that mediates deglutamylation of target proteins. Catalyzes the deglutamylation of polyglutamate side chains generated by post-translational polyglutamylation in proteins such as tubulins. Also removes gene-encoded polyglutamates from the carboxy-terminus of target proteins such as MYLK. Acts as a long-chain deglutamylase and specifically shortens long polyglutamate chains, while it is not able to remove the branching point glutamate, a process catalyzed by AGBL5/CCP5.
Cytoplasm. Cytoplasm>Cytosol. Nucleus. Mitochondrion.
Note: Localizes in both the cytoplasm and nuclei of interphase and dividing cells.
Belongs to the peptidase M14 family.
Restrictive clause
Affinity Biosciences tests all products strictly. Citations are provided as a resource for additional applications that have not been validated by Affinity Biosciences. Please choose the appropriate format for each application and consult Materials and Methods sections for additional details about the use of any product in these publications.
For Research Use Only.
Not for use in diagnostic or therapeutic procedures. Not for resale. Not for distribution without written consent. Affinity Biosciences will not be held responsible for patent infringement or other violations that may occur with the use of our products. Affinity Biosciences, Affinity Biosciences Logo and all other trademarks are the property of Affinity Biosciences LTD.